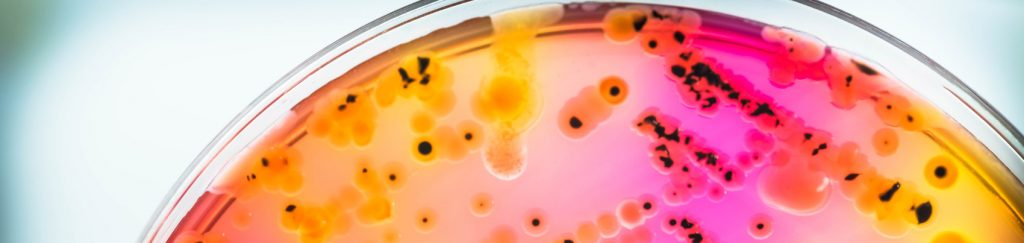

Быстрое и надежное подтверждение патогенов
Наборы Romer Labs для иммуномагнитного разделения для
Salmonella Enteritidis и не-O157 STEC являются
эквивалентами метода FDA,
утвержденными AOAC или перечисленными в
USDA FSIS MLG. Они предназначены для
подтверждения предполагаемых положительных образцов и экстракции отдельных серогрупп из комплексных образцов. Например, это возможно путем обогащения с помощью сред RapidChek
® SELECT™
Salmonella или RapidChek
® E. coli. Наборы разработаны с целью сокращения присутствия других серогрупп
Salmonella или
E. coli,, целевая серогруппа сконцентрирована для содействия во время экстракции патогена из селективных агаровых пластинок.
Быстрая и простая процедура
Для подтверждения каждый раствор с окрашенными магнитными частицами вносят в предполагаемую положительную среду обогащения и инкубируют с магнитными микроносителями. В случае присутствия патогена он связывается с магнитными частицами с помощью запатентованных антител. Затем используют магнит для концентрирования связанных магнитных частиц, а остатки среды обогащения удаляют, оставляя только магнитные частицы, связанные с целевым патогеном. Затем процедуры подтверждения продолжают в зависимости от референтного метода, применяемого к концентрированному образцу.
Надежные результаты
Множество сертификаций (
AOAC,
FDA,
NPIP,
USDA) подтверждают высокие стандарты аналитической точности и надежности результатов. RapidChek
® CONFIRM™ Salmonella Enteritidis
CONFIRM™ Salmonella Enteritidis
Сертификация и утверждения
AOAC (для мазковых проб смывов с поверхностей) Эквивалент метода FDA (для мазковых проб смывов с поверхностей) В обогащенном образце мазковой пробы смыва с поверхностей обычно присутствуют смешанные популяции штаммов
Salmonella что создает трудную среду для экстракции Группы D1, включая изоляты SE. Использование набора RapidChek
® CONFIRM™ IMS уменьшает присутствие других не-SE, видов
Salmonella с помощью этапов промывания, и позволяет концентрацию видов Группы D1.
Нажмите на артикул ниже для получения более детальной информации. | Артикул | | Количество |
| RapidChek® CONFIRM™ Salmonella Enteritidis IMS Beads |
| 10001400 | | 100 Tests |
| Артикул | Продукт | Количество |
| Дополнительные приспособления |
| 10001402 | Magnetic Rack, Rack to be used for wash steps of isolation protocol for RapidChek CONFIRMTM | 1 piece |